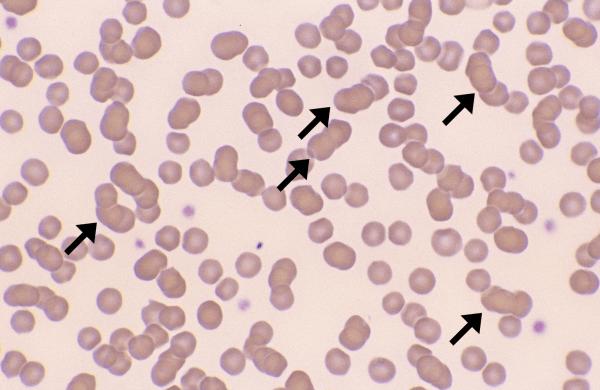
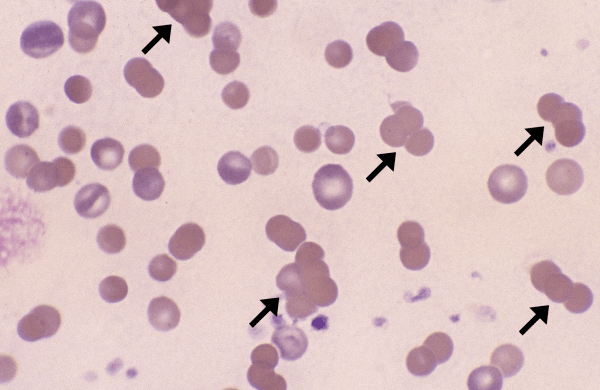

Rouleaux
Morphology: stacks of red blood cells (like a stack of coins). Look alike: agglutination. Rouleaux can be distinguished from agglutination with a saline dilution test: place one drop of blood on a… Read more Rouleaux →
Morphology: stacks of red blood cells (like a stack of coins). Look alike: agglutination. Rouleaux can be distinguished from agglutination with a saline dilution test: place one drop of blood on a… Read more Rouleaux →
Morphology: three-dimensional clumps of red blood cells. Caused by antibodies binding red blood cells together. Look alike: rouleaux. Agglutination can be distinguished from rouleaux with a saline dilution test: place one drop… Read more Agglutination →